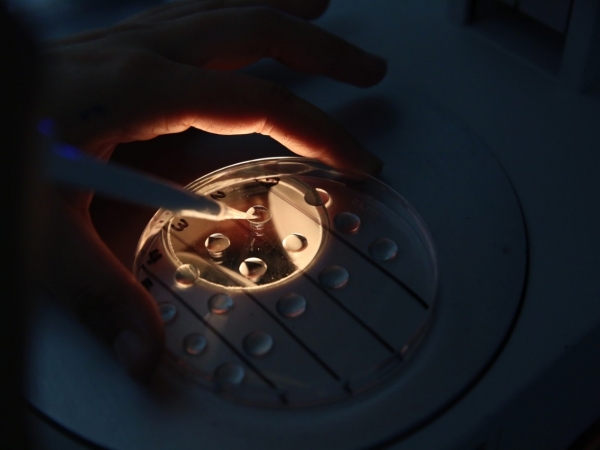
Foto: Divulgação

Digite o que procura
Digite o que procura
Foto: Divulgação
Foto: Divulgação
11/06/2021
Um novo projeto irá disponibilizar a tecnologia da transferência de embriões para pequenos e médios produtores de leite da região de Patrocínio (MG). Com o objetivo de promover o melhoramento genético dos rebanhos locais, a ABS e a Cooperativa Agropecuária de Patrocínio (Coopa) uniram forças para contribuir para o aumento da produtividade leiteira.
A iniciativa faz parte do projeto Mais Produtividade, desenvolvido pela ABS. Com a tecnologia de embriões e a consultoria do time técnico da empresa, os pequenos e médios produtores ligados à cooperativa terão acesso à genética de qualidade superior, adaptada especificamente para cada rebanho, no intuito de fomentar o melhoramento genético.
Na primeira fase do projeto, o objetivo é entregar entre 100 e 200 prenhezes, segundo conta o gerente de Negócios Embriões da ABS, Matheus Cunha.
“A ideia é proporcionar ao produtor uma genética de qualidade, à qual ele não teria acesso de outra forma. A ABS fornecerá a genética, enquanto os técnicos da Coopa estudarão a situação de cada rebanho e o manejo praticado nas propriedades, para garantir os melhores resultados”, comenta o gerente.
A maioria dos embriões será da raça Girolando – particularmente, Girolando ¾ – mas outros rebanhos terão prenhezes de Girolando ⅝ e 1/2, Gir, Jersey e Holandês. Um dos diferenciais do projeto é que ele também abrange aqueles produtores que ainda não fazem uso da inseminação artificial, oferecendo uma oportunidade de obter os benefícios associados às tecnologias que visam ao melhoramento genético.
“Para facilitar o acesso aos embriões, cada produtor pagará apenas pelas prenhezes que realmente forem concebidas no rebanho. A genética será selecionada com o objetivo de obter não só animais produtivos, mas também com rusticidade, um aspecto de grande relevância na nossa região”, diz o representante da ABS em Patrocínio, Daniel Ribeiro.
Para o presidente da Coopa, Fausto Amaral da Fonseca, o projeto é motivo de comemoração na cooperativa.
“Estamos muito esperançosos com a parceria feita com a ABS – em primeiro lugar, porque acreditamos no valor da genética e da transferência de embriões da empresa, e também pois sabemos a importância do melhoramento genético e da tecnologia para o nosso setor. É uma equipe especializada e competente para trazer ganhos marcantes para os rebanhos”, avalia Fausto.
Daniel Ribeiro ressalta, ainda, que a iniciativa poderá inspirar outros produtores da região a aderir a estas tecnologias reprodutivas, já que eles conhecerão o aumento de produtividade viabilizado por elas.
“A equipe ABS acompanhará todas as fases do processo, desde a sincronização até a implantação do embrião e o diagnóstico de gestação. Por sua vez, o time da Coopa oferecerá a assistência técnica na criação das progênies”, finaliza.
Fonte: Na Mídia Assessoria
